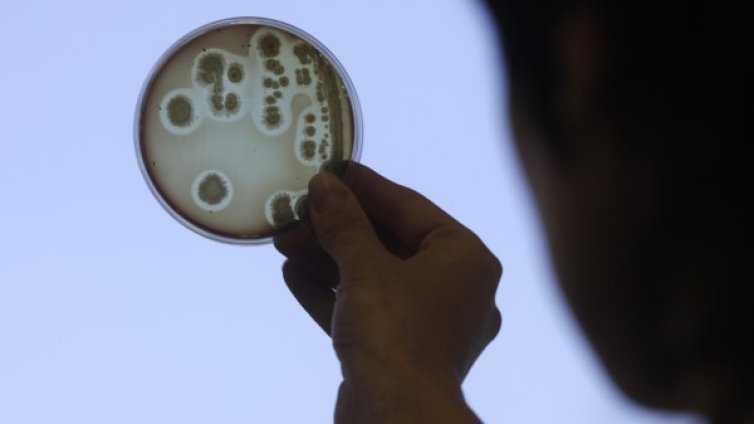

Новини
-
В кадър: Виолина Доцева ще е в главната роля във филма за Лили Иванова
-
Прогноза: До 4 години средната заплата в София ще мине 2500 евро бруто
-
Захарова: Парите, дадени на Киев, никога няма да бъдат върнати
-
Легендарният сръбски автомобил "Юго" се завръща на пазара с хибриден модел
-
Откриха тялото на издирвания след наводненията край Севлиево мъж
-
Слави: Време е цялата истина за случая "Петрохан" да стане ясна
-
Недостигът на медсестри ще закрие над 2200 места в детските ясли в София?
-
Руското посолство у нас: Днес почитаме създателите на първата славянска азбука
-
Старо интервю на Слави Трифонов с Дара предизвика възмущение онлайн ВИДЕО
-
Има опити за посегателства върху държавността ни от либерално-демократичното виждане
-
Тежко престъпление е по-вероятната версия за трагедията в Благоевград?
-
Какво представлява руската ракета "Орешник", която отново полетя към Украйна? ВИДЕО
-
Украйна използва цивилни, майки и таксиметрови шофьори, за да свалят руски дронове
-
Никола Цолов: Предателство е единствената правилна дума за чувствата ми в момента
-
Философията на Дугин: Руснаците не са войнствен народ, живеят мирно в окопите
-
Какво представлява руската ракета "Орешник", която отново полетя към Украйна? ВИДЕО
-
Тук не е за бедни: Пицата в София е 13 евро, колкото в Люксембург
-
Станаха лукс: Българите масово купуват по 100–300 грама череши, само за опитване ВИДЕО
-
Руското посолство у нас: Днес почитаме създателите на първата славянска азбука
-
Тайният руски проект "Скити": ядрени ракети на морското дъно
-
ДБ питат Радев: Русия агресор ли е срещу Украйна?

УЗФ търси отличниците на България
УЗФ търси отличниците на България  Делът на хората в риск от бедност в България намалява
Делът на хората в риск от бедност в България намалява  Как гимназистът Никола Маринов стъпи на математическия връх в света
Как гимназистът Никола Маринов стъпи на математическия връх в света  За първи път от 12 години предлагането на жилища в големите градове у нас изпреварва търсенето
За първи път от 12 години предлагането на жилища в големите градове у нас изпреварва търсенето  Китай позволи ключов лихвен процент да спадне до рекордно ниско ниво
Китай позволи ключов лихвен процент да спадне до рекордно ниско ниво  Мариана Хил: Изкуственият интелект няма да замени преводачите
Мариана Хил: Изкуственият интелект няма да замени преводачите 
 "Левски" за Георги Костадинов: Мъчно ни е, че губим капитана, но приветстваме директора
"Левски" за Георги Костадинов: Мъчно ни е, че губим капитана, но приветстваме директора  УЗФ търси отличниците на България
УЗФ търси отличниците на България  Влак помете училищен бус на спуснати бариери в Белгия, има жертви (ВИДЕО)
Влак помете училищен бус на спуснати бариери в Белгия, има жертви (ВИДЕО)  Кран изпусна купола на 169-годишна църква в Голема Раковица (+ВИДЕО)
Кран изпусна купола на 169-годишна църква в Голема Раковица (+ВИДЕО)  Откриха тялото на 55-годишния мъж, издирван при наводненията в Севлиево
Откриха тялото на 55-годишния мъж, издирван при наводненията в Севлиево  След потопа в Севлиево: Удавени животни, кал и огромни щети
След потопа в Севлиево: Удавени животни, кал и огромни щети 
 Арда развъртя метлата, махна каре
Арда развъртя метлата, махна каре  Еуфория в ПСЖ преди финала в ШЛ срещу Арсенал
Еуфория в ПСЖ преди финала в ШЛ срещу Арсенал  Мондиал 1986: Марадона изведе Аржентина до футболния връх
Мондиал 1986: Марадона изведе Аржентина до футболния връх  ЦСКА уволнява Ицо Янев. Чужденец става треньор
ЦСКА уволнява Ицо Янев. Чужденец става треньор  Разкриха го: Моуриньо вече готви трансферни удари за Реал Мадрид
Разкриха го: Моуриньо вече готви трансферни удари за Реал Мадрид  Левски с важно съобщение за "Мечката"
Левски с важно съобщение за "Мечката" 
 Цветове и графити: Louis Vuitton представи круизната си колекция за 2027 (+Снимки)
Цветове и графити: Louis Vuitton представи круизната си колекция за 2027 (+Снимки)  Задължителни подавки за Черешова задушница
Задължителни подавки за Черешова задушница  5 прически с минимална поддръжка
5 прически с минимална поддръжка  Как да разширим малкото жилище – идеи със сгъваеми мебели
Как да разширим малкото жилище – идеи със сгъваеми мебели  Как да преговаряте за заплатата си, ако сте на средна възраст
Как да преговаряте за заплатата си, ако сте на средна възраст  Генетикът д-р Балабански: Човек не може да избяга от гените си, но има начини да удължим живота си
Генетикът д-р Балабански: Човек не може да избяга от гените си, но има начини да удължим живота си 
 продава, Парцел, 600 m2 Пловдив област, с.Първенец, 37000 EUR
продава, Парцел, 600 m2 Пловдив област, с.Първенец, 37000 EUR  продава, Парцел, 498 m2 Пловдив област, гр.Куклен, 57500 EUR
продава, Парцел, 498 m2 Пловдив област, гр.Куклен, 57500 EUR  продава, Двустаен апартамент, 61 m2 Пловдив, Христо Смирненски, 94999 EUR
продава, Двустаен апартамент, 61 m2 Пловдив, Христо Смирненски, 94999 EUR  продава, Парцел, 600 m2 Пловдив област, с.Белащица, 79900 EUR
продава, Парцел, 600 m2 Пловдив област, с.Белащица, 79900 EUR  продава, Къща, 154 m2 Пловдив област, с.Труд, 119999 EUR
продава, Къща, 154 m2 Пловдив област, с.Труд, 119999 EUR  продава, Тристаен апартамент, 108 m2 Пазарджик, Устрем, 130000 EUR
продава, Тристаен апартамент, 108 m2 Пазарджик, Устрем, 130000 EUR 
 Почти 1 милион българи работят на минимална заплата, сочат данните на НАП
Почти 1 милион българи работят на минимална заплата, сочат данните на НАП  Коста Стоянов от "Възраждане" поиска равен достъп до НВО и матурите за деца с дислексия
Коста Стоянов от "Възраждане" поиска равен достъп до НВО и матурите за деца с дислексия  Засаждат нови дървета в центъра на Варна
Засаждат нови дървета в центъра на Варна  Близо 550 евро е средната пенсия за април заедно с великденската добавка
Близо 550 евро е средната пенсия за април заедно с великденската добавка  Заловиха нагли крадци във Варна
Заловиха нагли крадци във Варна  Продължава почистването на шахти в три района на Варна
Продължава почистването на шахти в три района на Варна 
 Гъби могат да превърнат лунната почва в плодородна земя
Гъби могат да превърнат лунната почва в плодородна земя  Как Хеопсовата пирамида устоява на земетресения в продължение на хилядолетия?
Как Хеопсовата пирамида устоява на земетресения в продължение на хилядолетия?  Доказано: Хората наистина имат „трето око“ и ето къде се намира то
Доказано: Хората наистина имат „трето око“ и ето къде се намира то  „Дронове глухарчета“ могат да картографират подземните лавови тунели на Марс
„Дронове глухарчета“ могат да картографират подземните лавови тунели на Марс  Ще ни позволи ли медицината да „надхитрим смъртта“?
Ще ни позволи ли медицината да „надхитрим смъртта“?  Откриха суперземя в орбита около близко до нас червено джудже
Откриха суперземя в орбита около близко до нас червено джудже